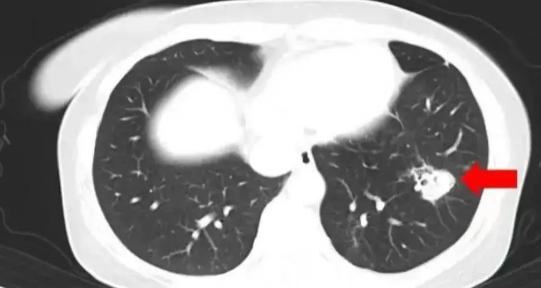

三亚买9斤水果蔬菜变6斤?官方通知!


“五一”假期市场供应充足,整体价格稳定。
财政部发布的方法是规范会计奖惩信息的核算和管理。
4 月 30 日至 5 月 2 当天,全国铁路旅客发送量持续 3 天空同比增长超过 10%,尤其是 5 月 1 日持续突破 2200 万和 2300 达到万2个关口 2311.9 人数刷新了历史最高纪录。
海上稠油田-中国海油深圳分公司番禺分公司番禺,我国应用无人平台远程开发。 11-12 平台投产。
中央气象台:5 月 3 日至 5 日本,我国北方将出现大风沙尘天气,局部降温 12 ℃。
3:0!在苏迪曼杯决赛中,国羽击败了日本队。
据侵华日军南京大屠杀遇难同胞纪念馆官方微博消息,刘贵祥于南京大屠杀生 2025 年 5 月 2 日子去世,享年 95 岁。

美国白宫:特朗普生日(6月6日 月 14 日本将举行阅兵。
美国宣布向乌出售 F-16 战斗机配件及配套服务。
巴基斯坦呼吁对印控克什米尔地区的枪击事件进行国际调查。
正式成为韩国国民力量党总统候选人的金文洙。

沈阳辽美中等职业学校学生集体退学 60 表演服装道歉:承诺回收服装,承担相关费用,已经达成和解。
三亚再次回应游客乘摩托艇出海遭遇暴雨:俱乐部没有配置全额指导员,停业整顿。
海南三亚市市场监督管理局、三亚市综合行政执法局 5 月 3 每日发布情况报告:5 月 1 日,有网友反映“在三亚买九斤水果变成六斤水果”的问题。三亚市市场监督管理局和综合行政执法局找到了移动摊贩。经调查,网友反映属实,已依法立案,拟按规定给予。 50000 人民币行政处罚。
江西望仙谷回应游客凌晨等不到接驳车:已经限流,接驳车运行时间较长。
在甘肃陇南开放学校等地安置游客:虽然条件有限,但不会让游客失望。
该男子在重庆渝中区点燃了自驾摩托车,并由群众和警察联合制服。 2 著名的群众受伤。


不要让做“良心饭”的人失望,尊重和珍惜,这样善良才能在真诚的回应中源远流长。
——《》

湖南浏阳推出的“中国烟花之乡”创意烟花秀《闪耀中国红》惊艳亮相。在一个多小时的烟花秀中, 无人机的“王炸”组合将科技与艺术相结合,勾勒出独特的场景。无论是现场观众还是网友,都获得了独特的浪漫感。

谁是假装全红的亲人?
痛心!5 美国交通事故中,中国公民遇难。
女性家中肺部发霉,快速检查,你家也有可能有肺部发霉的情况,→


监 制丨李绍飞
编 辑丨单镜宇
审 校丨严冬
来 源丨央视网
本文仅代表作者观点,版权归原创者所有,如需转载请在文中注明来源及作者名字。
免责声明:本文系转载编辑文章,仅作分享之用。如分享内容、图片侵犯到您的版权或非授权发布,请及时与我们联系进行审核处理或删除,您可以发送材料至邮箱:service@tojoy.com








